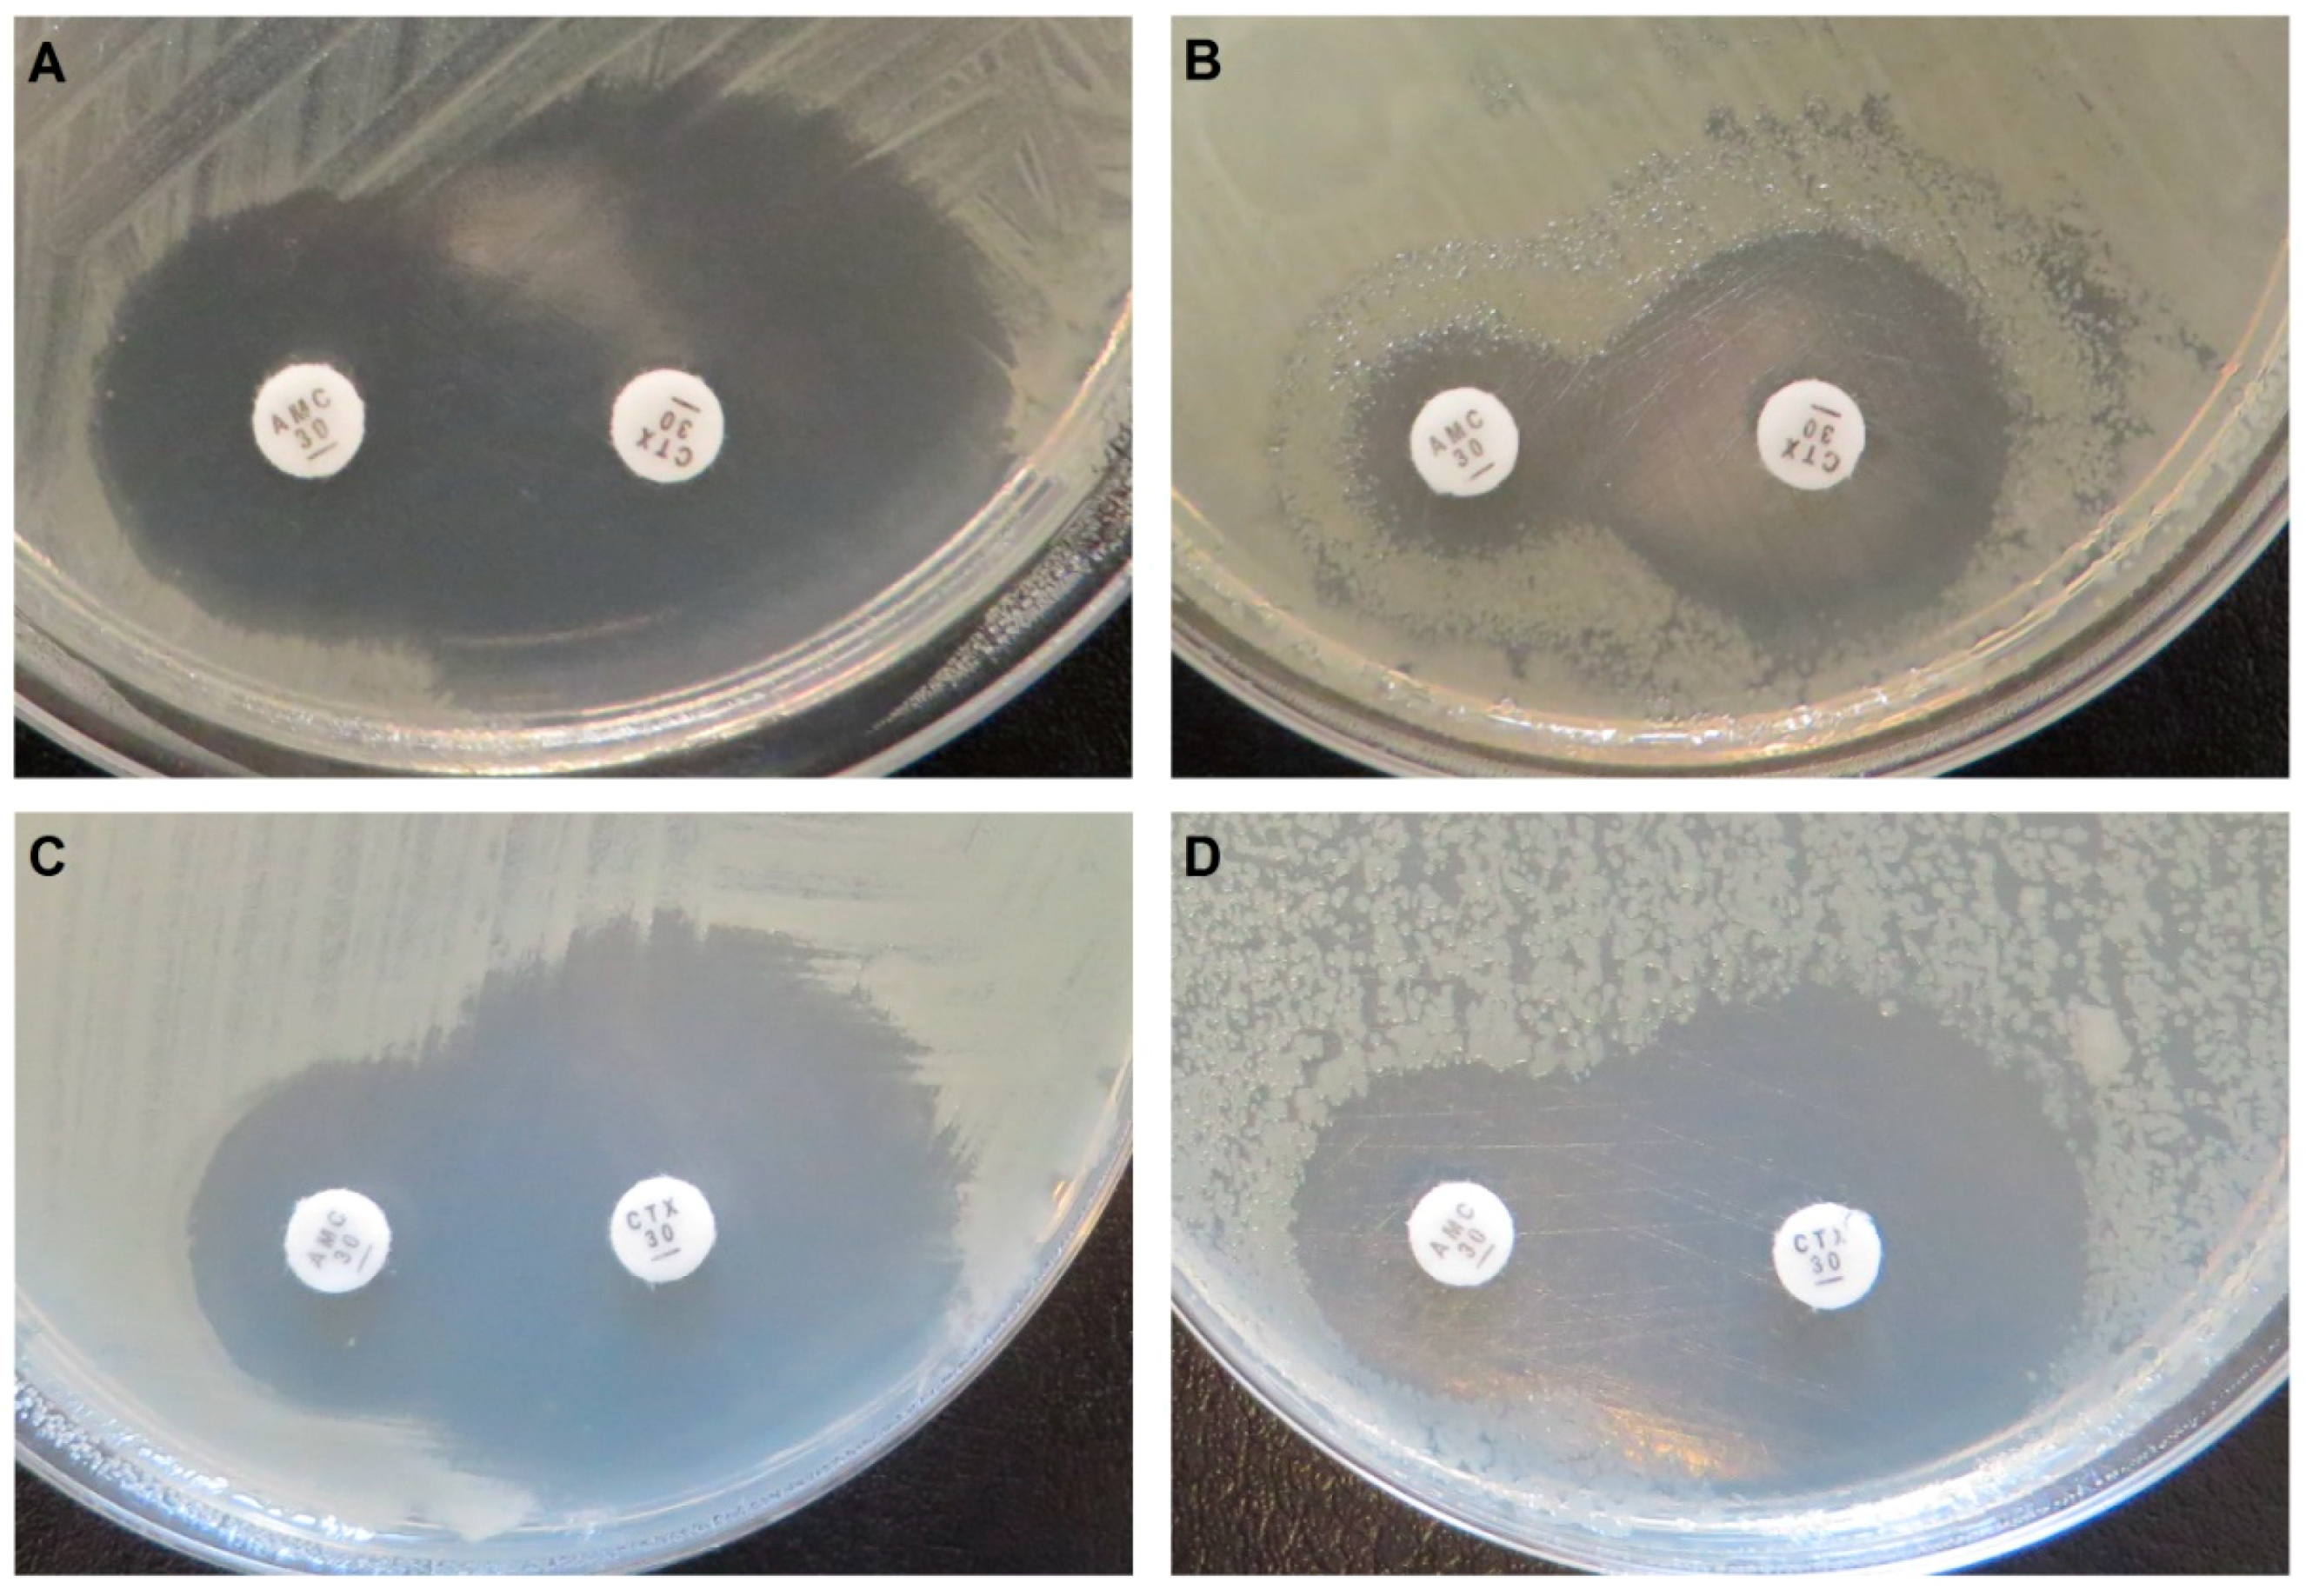

A Novel, Integron-Regulated, Class C β-Lactamase
Abstract
1. Introduction
2. Results
2.1. A Novel Class C β-lactamase Occurring in Gene Cassettes
2.2. Evidence for Class C β-lactamase Activity: Resistance Profile
2.3. Phylogenetic Affiliation within Class C β-lactamases
3. Discussion
4. Materials and Methods
4.1. Detection of ampC Gene Cassettes
4.2. Resistance Profile
4.2.1. Minimal Inhibitory Concentration Determination
4.2.2. Disk Diffusion Tests
4.3. Metagenome Search
4.4. Phylogenetic Tree
4.5. Amino Acid Sequence Analysis and Protein Model
Supplementary Materials
Author Contributions
Funding
Acknowledgments
Conflicts of Interest
References
- Bush, K.; Jacoby, G.A. Updated functional classification of β-lactamases. Antimicrob. Agents Chemother. 2010, 54, 969–976. [Google Scholar] [CrossRef]
- Thomson, K.S. Extended-Spectrum-β-Lactamase, AmpC, and Carbapenemase Issues. J. Clin. Microbiol. 2010, 48, 1019–1025. [Google Scholar] [CrossRef]
- Jacoby, G.A. AmpC β-lactamases. Clin. Microbiol. Rev. 2009, 22, 161–182. [Google Scholar] [CrossRef] [PubMed]
- Philippon, A.; Arlet, G.; Jacoby, G.A. Plasmid-determined AmpC-type β-lactamases. Antimicrob. Agents Chemother. 2002, 46, 1–11. [Google Scholar] [CrossRef] [PubMed]
- Reuland, E.A.; Halaby, T.; Hays, J.P.; de Jongh, D.M.C.; Snetselaar, H.D.R.; van Keulen, M.; Elders, P.J.M.; Savelkoul, P.H.M.; Vandenbroucke-Grauls, C.M.J.E.; Al Naiemi, N. Plasmid-mediated AmpC: Prevalence in community-acquired isolates in Amsterdam, The Netherlands, and risk factors for carriage. PLoS ONE 2015, 10, e0113033. [Google Scholar] [CrossRef] [PubMed]
- Jacoby, G.A.; Mills, D.M.; Chow, N. Role of β-lactamases and porins in resistance to ertapenem and other β-lactams in Klebsiella pneumoniae. Antimicrob. Agents Chemother. 2004, 48, 3203–3206. [Google Scholar] [CrossRef] [PubMed]
- Stapleton, P.D.; Shannon, K.P.; French, G.L. Carbapenem resistance in Escherichia coli associated with plasmid-determined CMY-4 β-lactamase production and loss of an outer membrane protein. Antimicrob. Agents Chemother. 1999, 43, 1206–1210. [Google Scholar] [CrossRef] [PubMed]
- Bradford, P.A.; Urban, C.; Mariano, N.; Projan, S.J.; Rahal, J.J.; Bush, K. Imipenem resistance in Klebsiella pneumoniae is associated with the combination of ACT-1, a plasmid-mediated AmpC β-lactamase, and the loss of an outer membrane protein. Antimicrob. Agents Chemother. 1997, 41, 563–569. [Google Scholar] [CrossRef] [PubMed]
- Livermore, D.M. Has the era of untreatable infections arrived? J. Antimicrob. Chemother. 2009, 64 (Suppl. 1), i29–i36. [Google Scholar] [CrossRef]
- Yamaguchi, T.; Kawahara, R.; Harada, K.; Teruya, S.; Nakayama, T.; Motooka, D.; Nakamura, S.; Nguyen, P.D.; Kumeda, Y.; Van Dang, C.; et al. The presence of colistin resistance gene mcr-1 and -3 in ESBL producing Escherichia coli isolated from food in Ho Chi Minh City, Vietnam. FEMS Microbiol. Lett. 2018, 365. [Google Scholar] [CrossRef]
- Hennequin, C.; Ravet, V.; Robin, F. Plasmids carrying DHA-1 β-lactamases. Eur. J. Clin. Microbiol. Infect. Dis. 2018, 37, 1197–1209. [Google Scholar] [CrossRef] [PubMed]
- Johnson, J.W.; Fisher, J.F.; Mobashery, S. Bacterial cell-wall recycling. Ann. N. Y. Acad. Sci. 2013, 1277, 54–75. [Google Scholar] [CrossRef] [PubMed]
- Zeng, X.; Lin, J. β-lactamase induction and cell wall metabolism in Gram-negative bacteria. Front. Microbiol. 2013, 4, 128. [Google Scholar] [CrossRef] [PubMed]
- Vadlamani, G.; Thomas, M.D.; Patel, T.R.; Donald, L.J.; Reeve, T.M.; Stetefeld, J.; Standing, K.G.; Vocadlo, D.J.; Mark, B.L. The β-lactamase gene regulator AmpR is a tetramer that recognizes and binds the D-Ala-D-Ala motif of its repressor UDP-N-acetylmuramic acid (MurNAc)-pentapeptide. J. Biol. Chem. 2015, 290, 2630–2643. [Google Scholar] [CrossRef] [PubMed]
- Honoré, N.; Nicolas, M.H.; Cole, S.T. Inducible cephalosporinase production in clinical isolates of Enterobacter cloacae is controlled by a regulatory gene that has been deleted from Escherichia coli. EMBO J. 1986, 5, 3709–3714. [Google Scholar] [CrossRef] [PubMed]
- Moya, B.; Juan, C.; Albertí, S.; Pérez, J.L.; Oliver, A. Benefit of having multiple ampD genes for acquiring β-lactam resistance without losing fitness and virulence in Pseudomonas aeruginosa. Antimicrob. Agents Chemother. 2008, 52, 3694–3700. [Google Scholar] [CrossRef]
- Galleni, M.; Amicosante, G.; Frère, J.M. A survey of the kinetic parameters of class C β-lactamases: Cephalosporins and other β-lactam compounds. Biochem. J. 1988, 255, 123–129. [Google Scholar] [CrossRef]
- Livermore, D.M. Clinical significance of beta-lactamase induction and stable derepression in gram-negative rods. Eur. J. Clin. Microbiol. 1987, 6, 439–445. [Google Scholar] [CrossRef]
- Jaurin, B.; Grundström, T.; Edlund, T.; Normark, S. The E. coli β-lactamase attenuator mediates growth rate-dependent regulation. Nature 1981, 290, 221–225. [Google Scholar] [CrossRef]
- Bou, G.; Martínez-Beltrán, J. Cloning, nucleotide sequencing, and analysis of the gene encoding an AmpC β-lactamase in Acinetobacter baumannii. Antimicrob. Agents Chemother. 2000, 44, 428–432. [Google Scholar] [CrossRef]
- Mulvey, M.R.; Bryce, E.; Boyd, D.A.; Ofner-Agostini, M.; Land, A.M.; Simor, A.E.; Paton, S. Molecular characterization of cefoxitin-resistant Escherichia coli from Canadian hospitals. Antimicrob. Agents Chemother. 2005, 49, 358–365. [Google Scholar] [CrossRef] [PubMed]
- Corvec, S.; Caroff, N.; Espaze, E.; Marraillac, J.; Reynaud, A. 11 Mutation in the ampC promoter increasing resistance to β-lactams in a clinical Escherichia coli strain. Antimicrob. Agents Chemother. 2002, 46, 3265–3267. [Google Scholar] [CrossRef] [PubMed]
- Reisbig, M.D.; Hossain, A.; Hanson, N.D. Factors influencing gene expression and resistance for Gram-negative organisms expressing plasmid-encoded ampC genes of Enterobacter origin. J. Antimicrob. Chemother. 2003, 51, 1141–1151. [Google Scholar] [CrossRef] [PubMed]
- Alksne, L.E.; Rasmussen, B.A. Expression of the AsbA1, OXA-12, and AsbM1 β-lactamases in Aeromonas jandaei AER 14 is coordinated by a two-component regulon. J. Bacteriol. 1997, 179, 2006–2013. [Google Scholar] [CrossRef]
- Zamorano, L.; Moyà, B.; Juan, C.; Mulet, X.; Blázquez, J.; Oliver, A. The Pseudomonas aeruginosa CreBC two-component system plays a major role in the response to β-lactams, fitness, biofilm growth, and global regulation. Antimicrob. Agents Chemother. 2014, 58, 5084–5095. [Google Scholar] [CrossRef]
- Bauernfeind, A.; Chong, Y.; Schweighart, S. Extended broad spectrum β-lactamase in Klebsiella pneumoniae including resistance to cephamycins. Infection 1989, 17, 316–321. [Google Scholar] [CrossRef]
- Thomson, K.S.; Smith Moland, E. Version 2000: The new β-lactamases of Gram-negative bacteria at the dawn of the new millennium. Microbes Infect. 2000, 2, 1225–1235. [Google Scholar] [CrossRef]
- Verdet, C.; Benzerara, Y.; Gautier, V.; Adam, O.; Ould-Hocine, Z.; Arlet, G. Emergence of DHA-1-producing Klebsiella spp. in the Parisian region: Genetic Organization of the ampC and ampR genes originating from Morganella morganii. Antimicrob. Agents Chemother. 2006, 50, 607–617. [Google Scholar] [CrossRef]
- Zamorano, L.; Miró, E.; Juan, C.; Gómez, L.; Bou, G.; González-López, J.J.; Martínez-Martínez, L.; Aracil, B.; Conejo, M.C.; Oliver, A.; et al. Mobile genetic elements related to the diffusion of plasmid-mediated AmpC β-lactamases or carbapenemases from Enterobacteriaceae: Findings from a multicenter study in Spain. Antimicrob. Agents Chemother. 2015, 59, 5260–5266. [Google Scholar] [CrossRef]
- Toleman, M.A.; Walsh, T.R. Combinatorial events of insertion sequences and ICE in Gram-negative bacteria. FEMS Microbiol. Rev. 2011, 35, 912–935. [Google Scholar] [CrossRef]
- Mollet, B.; Iida, S.; Arber, W. Gene organization and target specificity of the prokaryotic mobile genetic element IS26. Mol. Gen. Genet. 1985, 201, 198–203. [Google Scholar] [CrossRef] [PubMed]
- Jaurin, B.; Normark, S. Insertion of IS2 creates a novel ampC promoter in Escherichia coli. Cell 1983, 32, 809–816. [Google Scholar] [CrossRef]
- Nadjar, D.; Rouveau, M.; Verdet, C.; Donay, L.; Herrmann, J.; Lagrange, P.H.; Philippon, A.; Arlet, G. Outbreak of Klebsiella pneumoniae producing transferable AmpC-type β-lactamase (ACC-1) originating from Hafnia alvei. FEMS Microbiol. Lett. 2000, 187, 35–40. [Google Scholar] [CrossRef]
- Toleman, M.A.; Bennett, P.M.; Walsh, T.R. ISCR elements: Novel gene-capturing systems of the 21st century? Microbiol. Mol. Biol. Rev. 2006, 70, 296–316. [Google Scholar] [CrossRef] [PubMed]
- Pérez-Moreno, M.O.; Estepa, V.; Sáenz, Y.; Cortell-Ortolá, M.; Fort-Gallifa, I.; Ruiz, J.; Torres, C. Intrahospitalary dissemination of Klebsiella pneumoniae carrying blaDHA-1 and qnrB4 genes within a novel complex class 1 integron. Diagn. Microbiol. Infect. Dis. 2012, 73, 210–211. [Google Scholar] [CrossRef] [PubMed]
- Cambray, G.; Guerout, A.-M.; Mazel, D. Integrons. Annu. Rev. Genet. 2010, 44, 141–166. [Google Scholar] [CrossRef] [PubMed]
- Collis, C.M.; Hall, R.M. Expression of antibiotic resistance genes in the integrated cassettes of integrons. Antimicrob. Agents Chemother. 1995, 39, 155–162. [Google Scholar] [CrossRef]
- Mazel, D. Integrons: Agents of bacterial evolution. Nat. Rev. Microbiol. 2006, 4, 608–620. [Google Scholar] [CrossRef]
- Ghaly, T.M.; Chow, L.; Asher, A.J.; Waldron, L.S.; Gillings, M.R. Evolution of class 1 integrons: Mobilization and dispersal via food-borne bacteria. PLoS ONE 2017, 12, e0179169. [Google Scholar] [CrossRef]
- Gillings, M.; Boucher, Y.; Labbate, M.; Holmes, A.; Krishnan, S.; Holley, M.; Stokes, H.W. The evolution of class 1 integrons and the rise of antibiotic resistance. J. Bacteriol. 2008, 190, 5095–5100. [Google Scholar] [CrossRef]
- Gillings, M.R. DNA as a Pollutant: The Clinical Class 1 Integron. Curr. Pollut. Rep. 2018, 4, 49–55. [Google Scholar] [CrossRef]
- Partridge, S.R.; Tsafnat, G.; Coiera, E.; Iredell, J.R. Gene cassettes and cassette arrays in mobile resistance integrons. FEMS Microbiol. Rev. 2009, 33, 757–784. [Google Scholar] [CrossRef] [PubMed]
- Gatica, J.; Tripathi, V.; Green, S.; Manaia, C.M.; Berendonk, T.; Cacace, D.; Merlin, C.; Kreuzinger, N.; Schwartz, T.; Fatta-Kassinos, D.; et al. High Throughput Analysis of Integron Gene Cassettes in Wastewater Environments. Environ. Sci. Technol. 2016, 50, 11825–11836. [Google Scholar] [CrossRef] [PubMed]
- Wang, D.; Zhu, J.; Zhou, K.; Chen, J.; Yin, Z.; Feng, J.; Ma, L.; Zhou, D. Genetic characterization of novel class 1 Integrons In0, In1069 and In1287 to In1290, and the inference of In1069-associated integron evolution in Enterobacteriaceae. Antimicrob. Resist. Infect. Control 2017, 6, 84. [Google Scholar] [CrossRef] [PubMed]
- Bouheraoua, N.; Poirel, L.; Bourreau, B.; Bonnin, R.; Laroche, L.; Naas, T.; Nordmann, P. Integrase-Mediated Recombination of the bel-1 Gene Cassette Encoding the Extended-Spectrum β-Lactamase BEL-1. Antimicrob. Agents Chemother. 2018, 62. [Google Scholar] [CrossRef] [PubMed]
- Toleman, M.A.; Biedenbach, D.; Bennett, D.; Jones, R.N.; Walsh, T.R. Genetic characterization of a novel metallo-β-lactamase gene, blaIMP-13, harboured by a novel Tn5051-type transposon disseminating carbapenemase genes in Europe: Report from the SENTRY worldwide antimicrobial surveillance programme. J. Antimicrob. Chemother. 2003, 52, 583–590. [Google Scholar] [CrossRef] [PubMed]
- Lee, J.J.; Kim, M.-N.; Park, K.S.; Lee, J.H.; Karim, A.M.; Park, M.; Kim, J.H.; Lee, S.H. Complex Class 1 Integron Carrying qnrB62 and blaVIM-2 in a Citrobacter freundii Clinical Isolate. Antimicrob. Agents Chemother. 2016, 60, 6937–6940. [Google Scholar] [CrossRef][Green Version]
- Böhm, M.-E.; Razavi, M.; Marathe, N.P.; Flach, C.-F.; Larsson, D.G.J. Discovery of a novel integron-borne aminoglycoside resistance gene present in clinical pathogens by screening environmental bacterial communities. Microbiome 2020. [Google Scholar] [CrossRef]
- Jia, B.; Raphenya, A.R.; Alcock, B.; Waglechner, N.; Guo, P.; Tsang, K.K.; Lago, B.A.; Dave, B.M.; Pereira, S.; Sharma, A.N.; et al. CARD 2017: Expansion and model-centric curation of the comprehensive antibiotic resistance database. Nucleic Acids Res. 2017, 45, D566–D573. [Google Scholar] [CrossRef]
- Cury, J.; Jové, T.; Touchon, M.; Néron, B.; Rocha, E.P. Identification and analysis of integrons and cassette arrays in bacterial genomes. Nucleic Acids Res. 2016, 44, 4539–4550. [Google Scholar] [CrossRef]
- Razavi, M.; Marathe, N.P.; Gillings, M.R.; Flach, C.-F.; Kristiansson, E.; Joakim Larsson, D.G. Discovery of the fourth mobile sulfonamide resistance gene. Microbiome 2017, 5, 160. [Google Scholar] [CrossRef] [PubMed]
- Marathe, N.P.; Janzon, A.; Kotsakis, S.D.; Flach, C.-F.; Razavi, M.; Berglund, F.; Kristiansson, E.; Larsson, D.G.J. Functional metagenomics reveals a novel carbapenem-hydrolyzing mobile β-lactamase from Indian river sediments contaminated with antibiotic production waste. Environ. Int. 2018, 112, 279–286. [Google Scholar] [CrossRef] [PubMed]
- Marathe, N.P.; Pal, C.; Gaikwad, S.S.; Jonsson, V.; Kristiansson, E.; Larsson, D.G.J. Untreated urban waste contaminates Indian river sediments with resistance genes to last resort antibiotics. Water Res. 2017, 124, 388–397. [Google Scholar] [CrossRef] [PubMed]
- Antunes, N.T.; Lamoureaux, T.L.; Toth, M.; Stewart, N.K.; Frase, H.; Vakulenko, S.B. Class D β-lactamases: Are They All Carbapenemases? Antimicrob. Agents Chemother. 2014, 58, 2119–2125. [Google Scholar] [CrossRef] [PubMed]
- Bae, I.K.; Lee, Y.-N.; Jeong, S.H.; Hong, S.G.; Lee, J.H.; Lee, S.H.; Kim, H.J.; Youn, H. Genetic and biochemical characterization of GES-5, an extended-spectrum class A β-lactamase from Klebsiella pneumoniae. Diagn. Microbiol. Infect. Dis. 2007, 58, 465–468. [Google Scholar] [CrossRef] [PubMed]
- Holmes, A.J.; Gillings, M.R.; Nield, B.S.; Mabbutt, B.C.; Nevalainen, K.M.H.; Stokes, H.W. The gene cassette metagenome is a basic resource for bacterial genome evolution. Environ. Microbiol. 2003, 5, 383–394. [Google Scholar] [CrossRef] [PubMed]
- Ingram, P.R.; Inglis, T.J.J.; Vanzetti, T.R.; Henderson, B.A.; Harnett, G.B.; Murray, R.J. Comparison of methods for AmpC β-lactamase detection in Enterobacteriaceae. J. Med. Microbiol. 2011, 60, 715–721. [Google Scholar] [CrossRef]
- Tan, T.Y.; Ng, L.S.Y.; He, J.; Koh, T.H.; Hsu, L.Y. Evaluation of screening methods to detect plasmid-mediated AmpC in Escherichia coli, Klebsiella pneumoniae, and Proteus mirabilis. Antimicrob. Agents Chemother. 2009, 53, 146–149. [Google Scholar] [CrossRef]
- Drieux, L.; Brossier, F.; Sougakoff, W.; Jarlier, V. Phenotypic detection of extended-spectrum β-lactamase production in Enterobacteriaceae: Review and bench guide. Clin. Microbiol. Infect. 2008, 14 (Suppl. 1), 90–103. [Google Scholar] [CrossRef]
- Polsfuss, S.; Bloemberg, G.V.; Giger, J.; Meyer, V.; Böttger, E.C.; Hombach, M. Practical approach for reliable detection of AmpC β-lactamase-producing Enterobacteriaceae. J. Clin. Microbiol. 2011, 49, 2798–2803. [Google Scholar] [CrossRef]
- Coudron, P.E.; Moland, E.S.; Thomson, K.S. Occurrence and detection of AmpC β-lactamases among Escherichia coli, Klebsiella pneumoniae, and Proteus mirabilis isolates at a veterans medical center. J. Clin. Microbiol. 2000, 38, 1791–1796. [Google Scholar] [CrossRef] [PubMed]
- Smet, A.; Martel, A.; Persoons, D.; Dewulf, J.; Heyndrickx, M.; Catry, B.; Herman, L.; Haesebrouck, F.; Butaye, P. Diversity of extended-spectrum β-lactamases and class C β-lactamases among cloacal Escherichia coli Isolates in Belgian broiler farms. Antimicrob. Agents Chemother. 2008, 52, 1238–1243. [Google Scholar] [CrossRef] [PubMed]
- Luo, Y.; Dong, H.; Zhou, M.; Huang, Y.; Zhang, H.; He, W.; Sheng, H.; An, L. Lysobacter psychrotolerans sp. nov., isolated from soil in the Tianshan Mountains, Xinjiang, China. Int. J. Syst. Evol. Microbiol. 2019, 69, 926–931. [Google Scholar] [CrossRef] [PubMed]
- Wan, X.; Miller, J.M.; Rowley, S.J.; Hou, S.; Donachie, S.P. Draft Genome Sequence of a Novel Luteimonas sp. Strain from Coral Mucus, Hawai’i. Genome Announc. 2016, 4. [Google Scholar] [CrossRef]
- Allen, H.K.; Moe, L.A.; Rodbumrer, J.; Gaarder, A.; Handelsman, J. Functional metagenomics reveals diverse β-lactamases in a remote Alaskan soil. ISME J. 2009, 3, 243–251. [Google Scholar] [CrossRef]
- Hendriksen, R.S.; Munk, P.; Njage, P.; van Bunnik, B.; McNally, L.; Lukjancenko, O.; Röder, T.; Nieuwenhuijse, D.; Pedersen, S.K.; Kjeldgaard, J.; et al. Global monitoring of antimicrobial resistance based on metagenomics analyses of urban sewage. Nat. Commun. 2019, 10, 1124. [Google Scholar] [CrossRef]
- Marathe, N.P.; Berglund, F.; Razavi, M.; Pal, C.; Dröge, J.; Samant, S.; Kristiansson, E.; Larsson, D.G.J. Sewage effluent from an Indian hospital harbors novel carbapenemases and integron-borne antibiotic resistance genes. Microbiome 2019, 7, 97. [Google Scholar] [CrossRef]
- Kristiansson, E.; Fick, J.; Janzon, A.; Grabic, R.; Rutgersson, C.; Weijdegård, B.; Söderström, H.; Larsson, D.G.J. Pyrosequencing of antibiotic-contaminated river sediments reveals high levels of resistance and gene transfer elements. PLoS ONE 2011, 6, e17038. [Google Scholar] [CrossRef]
- Pal, C.; Bengtsson-Palme, J.; Kristiansson, E.; Larsson, D.G.J. The structure and diversity of human, animal and environmental resistomes. Microbiome 2016, 4, 54. [Google Scholar] [CrossRef]
- Ibarbalz, F.M.; Orellana, E.; Figuerola, E.L.M.; Erijman, L. Shotgun Metagenomic Profiles Have a High Capacity to Discriminate Samples of Activated Sludge According to Wastewater Type. Appl. Environ. Microbiol. 2016, 82, 5186–5196. [Google Scholar] [CrossRef]
- Gillings, M.R. Class 1 integrons as invasive species. Curr. Opin. Microbiol. 2017, 38, 10–15. [Google Scholar] [CrossRef] [PubMed]
- Escudero, J.A.; Loot, C.; Nivina, A.; Mazel, D. The Integron: Adaptation on Demand. Microbiol. Spect. 2015, 3, 139–161. [Google Scholar] [CrossRef] [PubMed]
- Bengtsson-Palme, J.; Kristiansson, E.; Larsson, D.G.J. Environmental factors influencing the development and spread of antibiotic resistance. FEMS Microbiol. Rev. 2017, 42. [Google Scholar] [CrossRef] [PubMed]
- Knox, J.R.; Moews, P.C.; Frere, J.M. Molecular evolution of bacterial β-lactam resistance. Chem. Biol. 1996, 3, 937–947. [Google Scholar] [CrossRef]
- Joris, B.; Ledent, P.; Dideberg, O.; Fonzé, E.; Lamotte-Brasseur, J.; Kelly, J.A.; Ghuysen, J.M.; Frère, J.M. Comparison of the sequences of class A β-lactamases and of the secondary structure elements of penicillin-recognizing proteins. Antimicrob. Agents Chemother. 1991, 35, 2294–2301. [Google Scholar] [CrossRef][Green Version]
- Pozzi, C.; Di Pisa, F.; De Luca, F.; Benvenuti, M.; Docquier, J.D.; Mangani, S. Atomic-Resolution Structure of a Class C β-Lactamase and Its Complex with Avibactam. ChemMedChem 2018, 13, 1437–1446. [Google Scholar] [CrossRef]
- Feller, G.; Zekhnini, Z.; Lamotte-Brasseur, J.; Gerday, C. Enzymes from cold-adapted microorganisms. The class C β-lactamase from the antarctic psychrophile Psychrobacter immobilis A5. Eur. J. Biochem. 1997, 244, 186–191. [Google Scholar] [CrossRef]
- Livermore, D.M.; Oakton, K.J.; Carter, M.W.; Warner, M. Activity of ertapenem (MK-0826) versus Enterobacteriaceae with potent β-lactamases. Antimicrob. Agents Chemother. 2001, 45, 2831–2837. [Google Scholar] [CrossRef]
- Mammeri, H.; Guillon, H.; Eb, F.; Nordmann, P. Phenotypic and biochemical comparison of the carbapenem-hydrolyzing activities of five plasmid-borne AmpC β-lactamases. Antimicrob. Agents Chemother. 2010, 54, 4556–4560. [Google Scholar] [CrossRef]
- Mainardi, J.L.; Mugnier, P.; Coutrot, A.; Buu-Hoï, A.; Collatz, E.; Gutmann, L. Carbapenem resistance in a clinical isolate of Citrobacter freundii. Antimicrob. Agents Chemother. 1997, 41, 2352–2354. [Google Scholar] [CrossRef]
- Mammeri, H.; Poirel, L.; Nordmann, P. Extension of the hydrolysis spectrum of AmpC β-lactamase of Escherichia coli due to amino acid insertion in the H-10 helix. J. Antimicrob. Chemother. 2007, 60, 490–494. [Google Scholar] [CrossRef] [PubMed]
- Dahyot, S.; Broutin, I.; de Champs, C.; Guillon, H.; Mammeri, H. Contribution of asparagine 346 residue to the carbapenemase activity of CMY-2 β-lactamase. FEMS Microbiol. Lett. 2013, 345, 147–153. [Google Scholar] [CrossRef] [PubMed][Green Version]
- Rodríguez-Martínez, J.-M.; Poirel, L.; Nordmann, P. Extended-spectrum cephalosporinases in Pseudomonas aeruginosa. Antimicrob. Agents Chemother. 2009, 53, 1766–1771. [Google Scholar] [CrossRef] [PubMed]
- Kotsakis, S.D.; Miriagou, V.; Tzelepi, E.; Tzouvelekis, L.S. Comparative biochemical and computational study of the role of naturally occurring mutations at Ambler positions 104 and 170 in GES β-lactamases. Antimicrob. Agents Chemother. 2010, 54, 4864–4871. [Google Scholar] [CrossRef]
- Poirel, L.; Naas, T.; Nordmann, P. Diversity, epidemiology, and genetics of class D β-lactamases. Antimicrob. Agents Chemother. 2010, 54, 24–38. [Google Scholar] [CrossRef]
- Juan, C.; Maciá, M.D.; Gutiérrez, O.; Vidal, C.; Pérez, J.L.; Oliver, A. Molecular Mechanisms of β-Lactam Resistance Mediated by AmpC Hyperproduction in Pseudomonas aeruginosa Clinical Strains. Antimicrob. Agents Chemother. 2005, 49, 4733–4738. [Google Scholar] [CrossRef]
- Juan, C.; Moyá, B.; Pérez, J.L.; Oliver, A. Stepwise Upregulation of the Pseudomonas aeruginosa Chromosomal Cephalosporinase Conferring High-Level β-Lactam Resistance Involves Three AmpD Homologues. Antimicrob. Agents Chemother. 2006, 50, 1780–1787. [Google Scholar] [CrossRef]
- Tracz, D.M.; Boyd, D.A.; Hizon, R.; Bryce, E.; McGeer, A.; Ofner-Agostini, M.; Simor, A.E.; Paton, S.; Mulvey, M.R. Canadian Nosocomial Infection Surveillance Program ampC gene expression in promoter mutants of cefoxitin-resistant Escherichia coli clinical isolates. FEMS Microbiol. Lett. 2007, 270, 265–271. [Google Scholar] [CrossRef]
- Corvec, S.; Caroff, N.; Espaze, E.; Giraudeau, C.; Drugeon, H.; Reynaud, A. AmpC cephalosporinase hyperproduction in Acinetobacter baumannii clinical strains. J. Antimicrob. Chemother. 2003, 52, 629–635. [Google Scholar] [CrossRef]
- Jové, T.; Da Re, S.; Denis, F.; Mazel, D.; Ploy, M.-C. Inverse correlation between promoter strength and excision activity in class 1 integrons. PLoS Genet. 2010, 6, e1000793. [Google Scholar] [CrossRef]
- Lévesque, C.; Brassard, S.; Lapointe, J.; Roy, P.H. Diversity and relative strength of tandem promoters for the antibiotic-resistance genes of several integrons. Gene 1994, 142, 49–54. [Google Scholar] [CrossRef]
- Mistry, J.; Finn, R.D.; Eddy, S.R.; Bateman, A.; Punta, M. Challenges in homology search: HMMER3 and convergent evolution of coiled-coil regions. Nucleic Acids Res. 2013, 41, e121. [Google Scholar] [CrossRef]
- Buchfink, B.; Xie, C.; Huson, D.H. Fast and sensitive protein alignment using DIAMOND. Nat. Methods 2015, 12, 59–60. [Google Scholar] [CrossRef]
- Hyatt, D.; Chen, G.-L.; Locascio, P.F.; Land, M.L.; Larimer, F.W.; Hauser, L.J. Prodigal: Prokaryotic gene recognition and translation initiation site identification. BMC Bioinform. 2010, 11, 119. [Google Scholar] [CrossRef]
- Fu, L.; Niu, B.; Zhu, Z.; Wu, S.; Li, W. CD-HIT: Accelerated for clustering the next-generation sequencing data. Bioinformatics 2012, 28, 3150–3152. [Google Scholar] [CrossRef]
- Li, W.; Godzik, A. Cd-hit: A fast program for clustering and comparing large sets of protein or nucleotide sequences. Bioinformatics 2006, 22, 1658–1659. [Google Scholar] [CrossRef]
- Flach, C.-F.; Boulund, F.; Kristiansson, E.; Larsson, D.J. Functional verification of computationally predicted qnr genes. Ann. Clin. Microbiol. Antimicrob. 2013, 12, 34. [Google Scholar] [CrossRef]
- Langmead, B.; Salzberg, S.L. Fast gapped-read alignment with Bowtie 2. Nat. Methods 2012, 9, 357–359. [Google Scholar] [CrossRef]
- Milne, I.; Bayer, M.; Cardle, L.; Shaw, P.; Stephen, G.; Wright, F.; Marshall, D. Tablet-next generation sequence assembly visualization. Bioinformatics 2010, 26, 401–402. [Google Scholar] [CrossRef]
- Katoh, K.; Standley, D.M. MAFFT multiple sequence alignment software version 7: Improvements in performance and usability. Mol. Biol. Evol. 2013, 30, 772–780. [Google Scholar] [CrossRef]
- Price, M.N.; Dehal, P.S.; Arkin, A.P. FastTree 2—Approximately maximum-likelihood trees for large alignments. PLoS ONE 2010, 5, e9490. [Google Scholar] [CrossRef]
- Letunic, I.; Bork, P. Interactive Tree of Life (iTOL) v4: Recent updates and new developments. Nucleic Acids Res. 2019, 47, W256–W259. [Google Scholar] [CrossRef]
- Almagro Armenteros, J.J.; Tsirigos, K.D.; Sønderby, C.K.; Petersen, T.N.; Winther, O.; Brunak, S.; von Heijne, G.; Nielsen, H. SignalP 5.0 improves signal peptide predictions using deep neural networks. Nat. Biotechnol. 2019, 37, 420–423. [Google Scholar] [CrossRef]
- Roy, A.; Kucukural, A.; Zhang, Y. I-TASSER: A unified platform for automated protein structure and function prediction. Nat. Protoc. 2010, 5, 725–738. [Google Scholar] [CrossRef]
- Yang, J.; Yan, R.; Roy, A.; Xu, D.; Poisson, J.; Zhang, Y. The I-TASSER Suite: Protein structure and function prediction. Nat. Methods 2015, 12, 7–8. [Google Scholar] [CrossRef]
- Zhang, Y. I-TASSER server for protein 3D structure prediction. BMC Bioinform. 2008, 9, 40. [Google Scholar] [CrossRef]

| β-Lactam | Empty Vector | blaIDC-1 | blaIDC-2 | |||||||||
|---|---|---|---|---|---|---|---|---|---|---|---|---|
| Cloxacillin | Cloxacillin | cloxacillin | ||||||||||
| Not Induced | Induced | Not Induced | Induced | Not Induced | Induced | Not Induced | Induced | Not Induced | Induced | Not Induced | Induced | |
| Amoxicillin + clavulanate | 21 | 22 | n.d. | n.d. | 24 | 13 | n.d. | n.d. | 21 | 20 | n.d. | n.d. |
| Cefotaxime | 35 | 35 | 36 | 37 | 38 | 24 | 38 | 36 | 35 | 32 | 35 | 43 |
| Ceftazidime | 32 | 31 | 32 | 33 | 32 | 27 | 34 | 35 | 31 | 32 | 32 | 41 |
| Cefoxitin | 27 | 29 | 31 | 31 | 28 | 17 | 32 | 29 | 28 | 25 | 31 | 29 |
| Cefepime | 33 | 33 | 34 | 34 | 36 | 37 | 36 | 37 | 33 | 43 | 35 | 44 |
| Ertapenem | 35 | 34 | 36 | 36 | 38 | 38 | 37 | 38 | 33 | 41 | 35 | 46 |
| Aztreonam | 32 | 32 | 35 | 35 | 36 | 30 | 37 | 37 | 33 | 36 | 34 | 43 |
| β-Lactam | Empty Vector | blaIDC-1 | blaIDC-2 | ||||||
|---|---|---|---|---|---|---|---|---|---|
| Not Induced | Induced | MIC Increase (Fold-Change) | Not Induced | Induced | MIC increase (Fold-Change) | Not Induced | Induced | MIC Increase (Fold-Change) | |
| Amoxicillin | 6 | 6 | - | 6 | 48 | 8 | 6 | 16 | 3 |
| Cefotaxime | 0.047 | 0.047 | - | 0.064 | 8 | 125 | 0.032 | 0.75 | 23 |
| Ceftazidime | 0.064 | 0.094 | - | 0.094 | 1.5 | 16 | 0.094 | 0.38 | 4 |
| Cefoxitin | 3 | 3 | - | 2 | 16 | 8 | 3 | 8 | 3 |
| Cefepime | 0.032 | 0.032 | - | 0.023 | 0.032 | - | 0.023 | 0.032 | - |
| Ertapenem | 0.003 | 0.003 | - | 0.004 | 0.016 | 4 | 0.003 | 0.004 | - |
| Imipenem | 0.50 | 0.50 | - | 0.38 | 0.50 | - | 0.38 | 0.38 | - |
| Aztreonam | 0.094 | 0.094 | - | 0.094 | 1.5 | 16 | 0.064 | 0.38 | 6 |
© 2020 by the authors. Licensee MDPI, Basel, Switzerland. This article is an open access article distributed under the terms and conditions of the Creative Commons Attribution (CC BY) license (http://creativecommons.org/licenses/by/4.0/).
Share and Cite
Böhm, M.-E.; Razavi, M.; Flach, C.-F.; Larsson, D.G.J. A Novel, Integron-Regulated, Class C β-Lactamase. Antibiotics 2020, 9, 123. https://doi.org/10.3390/antibiotics9030123
Böhm M-E, Razavi M, Flach C-F, Larsson DGJ. A Novel, Integron-Regulated, Class C β-Lactamase. Antibiotics. 2020; 9(3):123. https://doi.org/10.3390/antibiotics9030123
Chicago/Turabian StyleBöhm, Maria-Elisabeth, Mohammad Razavi, Carl-Fredrik Flach, and D. G. Joakim Larsson. 2020. "A Novel, Integron-Regulated, Class C β-Lactamase" Antibiotics 9, no. 3: 123. https://doi.org/10.3390/antibiotics9030123
APA StyleBöhm, M.-E., Razavi, M., Flach, C.-F., & Larsson, D. G. J. (2020). A Novel, Integron-Regulated, Class C β-Lactamase. Antibiotics, 9(3), 123. https://doi.org/10.3390/antibiotics9030123

